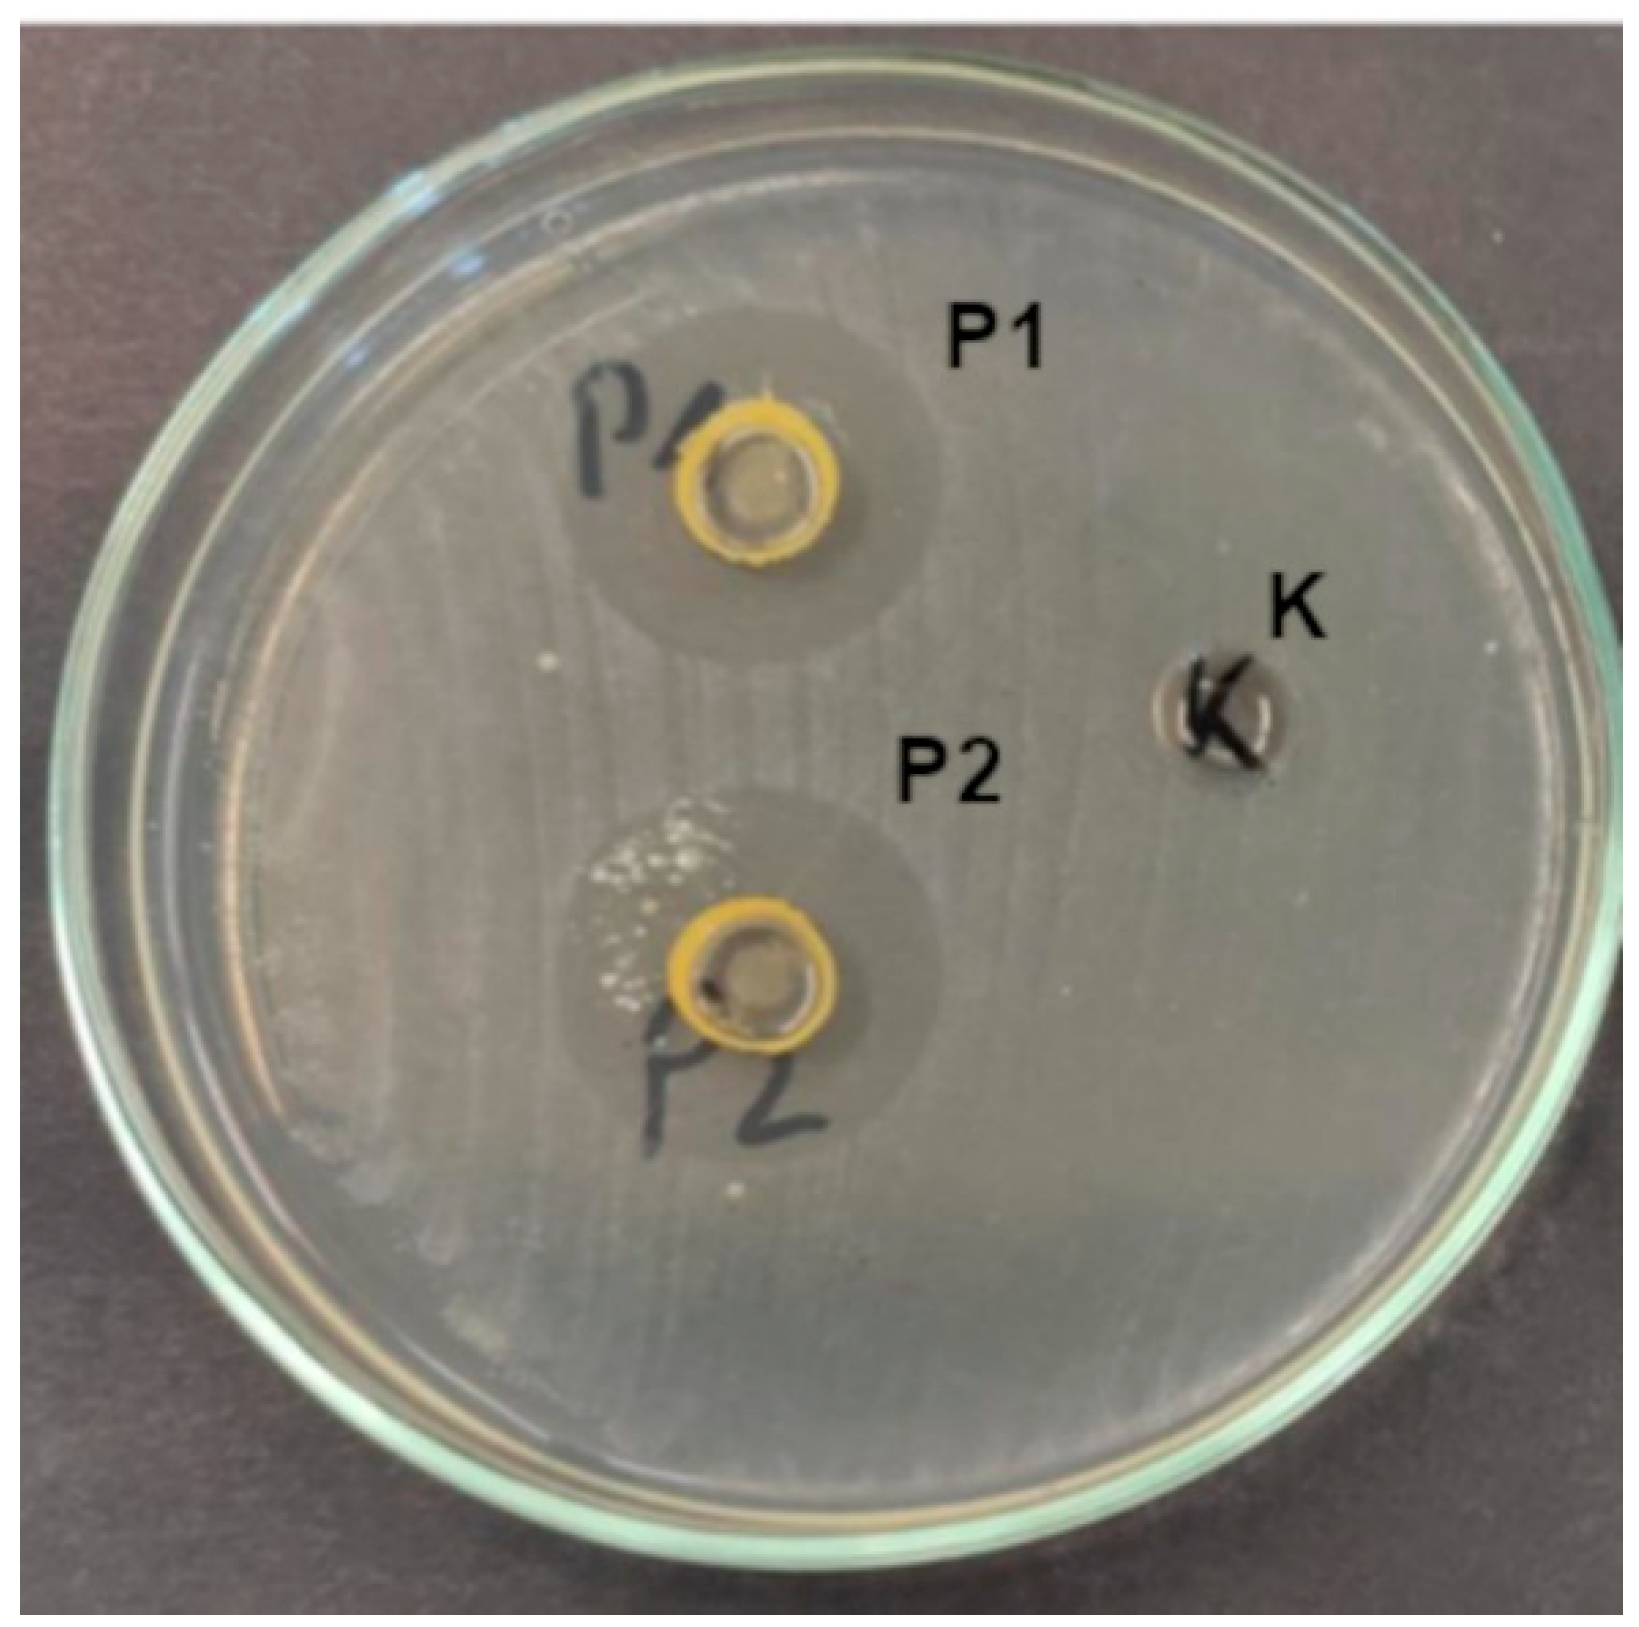
Ijms 26 08664 g005 Ijms 26 08664 g005

Synthesis and Investigation of Physicochemical and Microbial Properties of Composites Containing Encapsulated Propolis and Sea Buckthorn Oil in Pectin Matrix
Abstract
1. Introduction
2. Results
2.1. SEM
2.2. UV-Vis Spectroscopy
2.3. FTIR
2.4. Thickness and Mechanical Properties
2.5. Surface Color
2.6. Analysis DSC
2.7. Zeta Potential and Particle/Aggregate Sizes
2.8. Wettability and Free Surface Energy
2.9. Antioxidant Properties
2.9.1. Antioxidant Properties and Total Phenolic Content
2.9.2. Evaluation of Phenolic Compounds by UPLC-Q-TOF-MS
2.10. Microbiology
3. Materials and Methods
3.1. Materials
3.2. Methods
3.2.1. Preparation of Composites
3.2.2. SEM Miscroscopy
3.2.3. UV-Vis Spectroscopy
3.2.4. FTIR Spectroscopy
3.2.5. Thickness Measurement
3.2.6. Mechanical Properties of Composites
3.2.7. Color Measurements
3.2.8. Thermal Analysis
3.2.9. Dynamic Light Scattering (DLS) Measurements of Zeta Potential and Particle/Aggregate Sizes
3.2.10. Wettability and Free Surface Energy Determination
3.2.11. Antioxidant Properties
Analysis of Antioxidant Properties and Total Phenolic Content
Evaluation of Phenolic Compounds by UPLC-Q-TOF-MS
3.2.12. Microbiology
Isolation and Identification of Microorganisms
Antimicrobial Activity of Composites
3.2.13. Statistical Analysis
4. Conclusions
Supplementary Materials
Author Contributions
Funding
Institutional Review Board Statement
Informed Consent Statement
Data Availability Statement
Conflicts of Interest
References
- Nile, S.H.; Baskar, V.; Selvaraj, D.; Nile, A.; Xiao, J.; Kai, G. Nanotechnologies in food science: Applications, recent trends, and future perspectives. Nano-Micro Lett. 2020, 12, 45. [Google Scholar] [CrossRef] [PubMed]
- Dima, C.; Assadpour, E.; Dima, S.; Jafari, S.M. Bioactive-loaded nanocarriers for functional foods: From designing to bioavailability. Curr. Opin. Food Sci. 2020, 33, 21–29. [Google Scholar] [CrossRef]
- Jummai, J.M.; Balogu, V.T. A Review On Novel Use Of Nanotechnology In Food And Dairy Industry To Enhanced Functional And Nutritional Qualities. 2023. Available online: http://irepo.futminna.edu.ng:8080/jspui/handle/123456789/26860 (accessed on 20 May 2025).
- Kumar, A.; Samtiya, M.; Sharma, A.; Dhiman, S.; Krishan, B.; Singhi, P.; Dhewa, T. Application of Nanotechnology to Developing Nutraceuticals and Functional Foods. In Functional Foods and Nutraceuticals: Chemistry, Health Benefits and the Way Forward; Springer: Berlin/Heidelberg, Germany, 2024; pp. 277–285. [Google Scholar]
- Diniz do Nascimento, L.; Barbosa de Moraes, A.A.; Santana da Costa, K.; Pereira Galúcio, J.M.; Taube, P.S.; Leal Costa, C.M.; Neves Cruz, J.; de Aguiar Andrade, E.H.; Guerreiro de Faria, L.J. Bioactive natural compounds and antioxidant activity of essential oils from spice plants: New findings and potential applications. Biomolecules 2020, 10, 988. [Google Scholar] [CrossRef]
- Zhao, Y.-S.; Eweys, A.S.; Zhang, J.-Y.; Zhu, Y.; Bai, J.; Darwesh, O.M.; Zhang, H.-B.; Xiao, X. Fermentation affects the antioxidant activity of plant-based food material through the release and production of bioactive components. Antioxidants 2021, 10, 2004. [Google Scholar] [CrossRef]
- Noce, A.; Di Lauro, M.; Di Daniele, F.; Pietroboni Zaitseva, A.; Marrone, G.; Borboni, P.; Di Daniele, N. Natural bioactive compounds useful in clinical management of metabolic syndrome. Nutrients 2021, 13, 630. [Google Scholar] [CrossRef]
- Ramírez-Moreno, E.; Arias-Rico, J.; Jiménez-Sánchez, R.C.; Estrada-Luna, D.; Jiménez-Osorio, A.S.; Zafra-Rojas, Q.Y.; Ariza-Ortega, J.A.; Flores-Chávez, O.R.; Morales-Castillejos, L.; Sandoval-Gallegos, E.M. Role of bioactive compounds in obesity: Metabolic mechanism focused on inflammation. Foods 2022, 11, 1232. [Google Scholar] [CrossRef]
- Rangel-Huerta, O.D.; Pastor-Villaescusa, B.; Aguilera, C.M.; Gil, A. A systematic review of the efficacy of bioactive compounds in cardiovascular disease: Phenolic compounds. Nutrients 2015, 7, 5177–5216. [Google Scholar] [CrossRef]
- Sharifi-Rad, J.; Rodrigues, C.F.; Sharopov, F.; Docea, A.O.; Can Karaca, A.; Sharifi-Rad, M.; Kahveci Karıncaoglu, D.; Gülseren, G.; Şenol, E.; Demircan, E. Diet, lifestyle and cardiovascular diseases: Linking pathophysiology to cardioprotective effects of natural bioactive compounds. Int. J. Environ. Res. Public Health 2020, 17, 2326. [Google Scholar] [CrossRef]
- Sindhu, R.K.; Goyal, A.; Algın Yapar, E.; Cavalu, S. Bioactive compounds and nanodelivery perspectives for treatment of cardiovascular diseases. Appl. Sci. 2021, 11, 11031. [Google Scholar] [CrossRef]
- Tache, A.M.; Dinu, L.D.; Vamanu, E. Novel insights on plant extracts to prevent and treat recurrent urinary tract infections. Appl. Sci. 2022, 12, 2635. [Google Scholar] [CrossRef]
- Vamanu, E.; Dinu, L.D.; Luntraru, C.M.; Suciu, A. In vitro coliform resistance to bioactive compounds in urinary infection, assessed in a lab catheterization model. Appl. Sci. 2021, 11, 4315. [Google Scholar] [CrossRef]
- Shoaib, S.; Ansari, M.A.; Fatease, A.A.; Safhi, A.Y.; Hani, U.; Jahan, R.; Alomary, M.N.; Ansari, M.N.; Ahmed, N.; Wahab, S. Plant-derived bioactive compounds in the management of neurodegenerative disorders: Challenges, future directions and molecular mechanisms involved in neuroprotection. Pharmaceutics 2023, 15, 749. [Google Scholar] [CrossRef]
- Franco, G.A.; Interdonato, L.; Cordaro, M.; Cuzzocrea, S.; Di Paola, R. Bioactive compounds of the Mediterranean diet as nutritional support to fight neurodegenerative disease. Int. J. Mol. Sci. 2023, 24, 7318. [Google Scholar] [CrossRef]
- Yao, Y.; Zhou, Y.; Liu, L.; Xu, Y.; Chen, Q.; Wang, Y.; Wu, S.; Deng, Y.; Zhang, J.; Shao, A. Nanoparticle-based drug delivery in cancer therapy and its role in overcoming drug resistance. Front. Mol. Biosci. 2020, 7, 193. [Google Scholar] [CrossRef]
- Fonseca, L.R.; Silva, G.R.; Luís, Â.; Cardoso, H.J.; Correia, S.; Vaz, C.V.; Duarte, A.P.; Socorro, S. Sweet cherries as anti-cancer agents: From bioactive compounds to function. Molecules 2021, 26, 2941. [Google Scholar] [CrossRef] [PubMed]
- Aziz, A.; Noreen, S.; Khalid, W.; Mubarik, F.; Niazi, M.K.; Koraqi, H.; Ali, A.; Lima, C.M.G.; Alansari, W.S.; Eskandrani, A.A. Extraction of bioactive compounds from different vegetable sprouts and their potential role in the formulation of functional foods against various disorders: A literature-based review. Molecules 2022, 27, 7320. [Google Scholar] [CrossRef] [PubMed]
- Enciso-Martínez, Y.; Zuñiga-Martínez, B.S.; Ayala-Zavala, J.F.; Domínguez-Avila, J.A.; González-Aguilar, G.A.; Viuda-Martos, M. Agro-Industrial By-Products of Plant Origin: Therapeutic Uses as well as antimicrobial and antioxidant activity. Biomolecules 2024, 14, 762. [Google Scholar] [CrossRef] [PubMed]
- ElGamal, R.; Song, C.; Rayan, A.M.; Liu, C.; Al-Rejaie, S.; ElMasry, G. Thermal degradation of bioactive compounds during drying process of horticultural and agronomic products: A comprehensive overview. Agronomy 2023, 13, 1580. [Google Scholar] [CrossRef]
- Ling, J.K.U.; Sam, J.H.; Jeevanandam, J.; Chan, Y.S.; Nandong, J. Thermal degradation of antioxidant compounds: Effects of parameters, thermal degradation kinetics, and formulation strategies. Food Bioprocess Technol. 2022, 15, 1919–1935. [Google Scholar] [CrossRef]
- Pateiro, M.; Gómez, B.; Munekata, P.E.; Barba, F.J.; Putnik, P.; Kovačević, D.B.; Lorenzo, J.M. Nanoencapsulation of promising bioactive compounds to improve their absorption, stability, functionality and the appearance of the final food products. Molecules 2021, 26, 1547. [Google Scholar] [CrossRef]
- Zabot, G.L.; Schaefer Rodrigues, F.; Polano Ody, L.; Vinícius Tres, M.; Herrera, E.; Palacin, H.; Córdova-Ramos, J.S.; Best, I.; Olivera-Montenegro, L. Encapsulation of bioactive compounds for food and agricultural applications. Polymers 2022, 14, 4194. [Google Scholar] [CrossRef]
- Yusuf, A.; Almotairy, A.R.Z.; Henidi, H.; Alshehri, O.Y.; Aldughaim, M.S. Nanoparticles as drug delivery systems: A review of the implication of nanoparticles’ physicochemical properties on responses in biological systems. Polymers 2023, 15, 1596. [Google Scholar] [CrossRef]
- Kurek, M.; Benaida-Debbache, N.; Elez Garofulić, I.; Galić, K.; Avallone, S.; Voilley, A.; Waché, Y. Antioxidants and bioactive compounds in food: Critical review of issues and prospects. Antioxidants 2022, 11, 742. [Google Scholar] [CrossRef]
- Khachatryan, G.; Pląder, J.; Piechowicz, K.; Witczak, T.; Liszka-Skoczylas, M.; Witczak, M.; Gałkowska, D.; Duraczyńska, D.; Hunter, W.; Waradzyn, A. Preparation and Study of the Physicochemical and Functional Properties of Nano/Micromicellar Structures Containing Chokeberry Fruit Pomace Extracts Using Egg White and Egg Yolk. Int. J. Mol. Sci. 2024, 25, 8405. [Google Scholar] [CrossRef]
- Turek, K.; Khachatryan, G.; Khachatryan, K.; Krystyjan, M. An innovative method for the production of yoghurt fortified with walnut oil nanocapsules and characteristics of functional properties in relation to conventional yoghurts. Foods 2023, 12, 3842. [Google Scholar] [CrossRef] [PubMed]
- Khachatryan, G.; Khachatryan, K.; Krystyjan, M.; Krzemińska-Fiedorowicz, L.; Lenart-Boroń, A.; Białecka, A.; Krupka, M.; Krzan, M.; Blaszyńska, K.; Hanula, M. Synthesis and investigation of physicochemical and biological properties of films containing encapsulated propolis in hyaluronic matrix. Polymers 2023, 15, 1271. [Google Scholar] [CrossRef] [PubMed]
- Massel, V.; Fang, Y.; Corredig, M. Pectin nanoemulsions in multiple emulsions: Stability and encapsulation efficiency. Food Res. Int. 2021, 139, 109950. [Google Scholar] [CrossRef]
- Benassi, L.; Alessandri, I.; Vassalini, I. Assessing green methods for pectin extraction from waste orange peels. Molecules 2021, 26, 1766. [Google Scholar] [CrossRef]
- Jia, Y.; Wang, C.; Khalifa, I.; Zhu, Y.; Wang, Z.; Chen, H.; Liang, X.; Zhang, H.; Hu, L.; Yang, W. Pectin: A review with recent advances in the emerging revolution and multiscale evaluation approaches of its emulsifying characteristics. Food Hydrocoll. 2024, 157, 110428. [Google Scholar] [CrossRef]
- Roy, S.; Priyadarshi, R.; Łopusiewicz, Ł.; Biswas, D.; Chandel, V.; Rhim, J.-W. Recent progress in pectin extraction, characterization, and pectin-based films for active food packaging applications: A review. Int. J. Biol. Macromol. 2023, 239, 124248. [Google Scholar] [CrossRef]
- Chandel, V.; Biswas, D.; Roy, S.; Vaidya, D.; Verma, A.; Gupta, A. Current advancements in pectin: Extraction, properties and multifunctional applications. Foods 2022, 11, 2683. [Google Scholar] [CrossRef]
- Pu, Y.; Jiang, H.; Zhang, Y.; Cao, J.; Jiang, W. Advances in propolis and propolis functionalized coatings and films for fruits and vegetables preservation. Food Chem. 2023, 414, 135662. [Google Scholar] [CrossRef]
- Chavda, V.P.; Chaudhari, A.Z.; Teli, D.; Balar, P.; Vora, L. Propolis and Their Active Constituents for Chronic Diseases. Biomedicines 2023, 11, 259. [Google Scholar] [CrossRef]
- El-Sakhawy, M.; Salama, A.; Mohamed, S.A.A. Propolis applications in food industries and packaging. Biomass Convers. Biorefinery 2024, 14, 13731–13746. [Google Scholar] [CrossRef]
- Ibáñez, B.; Melero, A.; Montoro, A.; San Onofre, N.; Soriano, J.M. Radioprotective Effects from Propolis: A Review. Molecules 2023, 28, 5842. [Google Scholar] [CrossRef]
- Adefegha, S.A.; Oboh, G.; Oluokun, O.O. Food bioactives: The food image behind the curtain of health promotion and prevention against several degenerative diseases. Stud. Nat. Prod. Chem. 2022, 72, 391–421. [Google Scholar]
- Segueni, N.; Boutaghane, N.; Asma, S.T.; Tas, N.; Acaroz, U.; Arslan-Acaroz, D.; Shah, S.R.A.; Abdellatieff, H.A.; Akkal, S.; Peñalver, R.; et al. Review on Propolis Applications in Food Preservation and Active Packaging. Plants 2023, 12, 1654. [Google Scholar] [CrossRef] [PubMed]
- Rahman, S.; Talukdar, N.C.; Patowary, K.; Mohanta, Y.K. Propolis from the North-East region of India exhibits potent antioxidant and anticancer activity against breast cancer cells. Biocatal. Agric. Biotechnol. 2024, 59, 103269. [Google Scholar] [CrossRef]
- Chacon, W.D.C.; Monteiro, A.R.; Verruck, S.; Valencia, G.A. Optimization model of starch nanoparticles production loaded with phenolic compounds from green propolis extract. J. Polym. Environ. 2024, 32, 3946–3960. [Google Scholar] [CrossRef]
- González Montiel, L.; León-López, A.; García-Ceja, A.; Franco-Fernández, M.J.; Pérez-Soto, E.; Cenobio-Galindo, A.d.J.; Campos-Montiel, R.G.; Aguirre-Álvarez, G. Stability, content of bioactive compounds and antioxidant activity of emulsions with propolis extracts during simulated in vitro digestion. Foods 2024, 13, 779. [Google Scholar] [CrossRef]
- Suryakumar, G.; Rathor, R.; Singh, S.N.; Kumar, B. Medicinal and Nutraceutical Properties of Seabuckthorn. In The Seabuckthorn Genome; Springer: Berlin/Heidelberg, Germany, 2022; pp. 283–300. [Google Scholar]
- Samanci, A.E.T.; Muluk, N.B.; Samanci, T.; Cingi, C. Propolis: Prevention and Healing Effects in Otorhinolaryngology; Springer: Berlin/Heidelberg, Germany, 2024. [Google Scholar]
- Song, A.; Li, Y.; Wang, W.; Hu, Y.; Xu, J.; Xu, Z.; Zhou, L.; Liu, J. Revealing the effect of sea buckthorn oil, fish oil and structured lipid on intestinal microbiota, colonic short chain fatty acid composition and serum lipid profiles in vivo. Nat. Prod. Bioprospect. 2024, 14, 41. [Google Scholar] [CrossRef]
- Wirkowska-Wojdyła, M.; Ostrowska-Ligęza, E.; Górska, A.; Brzezińska, R.; Piasecka, I. Assessment of the nutritional potential and resistance to oxidation of sea buckthorn and rosehip oils. Appl. Sci. 2024, 14, 1867. [Google Scholar] [CrossRef]
- Chen, Y.; Cai, Y.; Wang, K.; Wang, Y. Bioactive compounds in sea buckthorn and their efficacy in preventing and treating metabolic syndrome. Foods 2023, 12, 1985. [Google Scholar] [CrossRef] [PubMed]
- Shen, Z.; Dai, J.; Yang, X.; Liu, Y.; Liu, L.; Huang, Y.; Wang, L.; Chen, P.; Chen, X.; Zhang, C. Comparison of sea buckthorn fruit oil nanoemulsions stabilized by protein-polysaccharide conjugates prepared using β-glucan from various sources. Food Chem. 2024, 457, 140098. [Google Scholar] [CrossRef]
- Sun, R.; Zhang, M.; Zhao, J.; Lu, M.; Hao, J.; Guan, X.; Li, C. Anti-atherosclerotic effect of sea buckthorn (Hippophae Rhamnoides Linn) and its molecular mechanism. J. Funct. Foods 2024, 117, 106248. [Google Scholar] [CrossRef]
- Lin, J.; Meng, H.; Guo, X.; Yu, S. Enhancing the emulsification and photostability properties of pectin from different sources using Genipin crosslinking technique. Foods 2022, 11, 2392. [Google Scholar] [CrossRef]
- Lin, J.; Tang, Z.-s.; Brennan, C.S.; Zeng, X.-A. Thermomechanically micronized sugar beet pulp: Dissociation mechanism, physicochemical characteristics, and emulsifying properties. Food Res. Int. 2022, 160, 111675. [Google Scholar] [CrossRef]
- Adaškevičiūtė, V.; Kaškonienė, V.; Kaškonas, P.; Barčauskaitė, K.; Maruška, A. Comparison of physicochemical properties of bee pollen with other bee products. Biomolecules 2019, 9, 819. [Google Scholar] [CrossRef]
- Zhang, H.; Song, G.; Ma, W.; Guo, M.; Ling, X.; Yu, D.; Zhou, W.; Li, L. Microencapsulation protects the biological activity of sea buckthorn seed oil. Front. Nutr. 2023, 9, 1043879. [Google Scholar] [CrossRef]
- Kowalczyk, D.; Karaś, M.; Kazimierczak, W.; Skrzypek, T.; Wiater, A.; Bartkowiak, A.; Basiura-Cembala, M. A Comparative Study on the Structural, Physicochemical, Release, and Antioxidant Properties of Sodium Casein and Gelatin Films Containing Sea Buckthorn Oil. Polymers 2025, 17, 320. [Google Scholar] [CrossRef] [PubMed]
- Topală, C.M.; Ducu, C. Spectroscopic study of sea buckthorn extracts. Curr. Trends Nat. Sci. 2014, 3, 48–53. [Google Scholar]
- Kozioł, A.; Środa-Pomianek, K.; Górniak, A.; Wikiera, A.; Cyprych, K.; Malik, M. Structural determination of pectins by spectroscopy methods. Coatings 2022, 12, 546. [Google Scholar] [CrossRef]
- Wani, K.M.; Uppaluri, R.V. Characterization of pectin extracted from pomelo peel using pulsed ultrasound assisted extraction and acidic hot water extraction process. Appl. Food Res. 2023, 3, 100345. [Google Scholar] [CrossRef]
- Jandosov, J.; Alavijeh, M.; Sultakhan, S.; Baimenov, A.; Bernardo, M.; Sakipova, Z.; Azat, S.; Lyubchyk, S.; Zhylybayeva, N.; Naurzbayeva, G. Activated carbon/pectin composite enterosorbent for human protection from intoxication with xenobiotics Pb (II) and sodium diclofenac. Molecules 2022, 27, 2296. [Google Scholar] [CrossRef]
- Kala, S.; Sogan, N.; Naik, S.; Agarwal, A.; Kumar, J. Impregnation of pectin-cedarwood essential oil nanocapsules onto mini cotton bag improves larvicidal performances. Sci. Rep. 2020, 10, 14107. [Google Scholar] [CrossRef]
- Ibrahim, N.; Zakaria, A.J.; Ismail, Z.; Ahmad, Y.; Mohd, K. Application of GCMS and FTIR fingerprinting in discriminating two species of Malaysian stingless bees propolis. Int. J. Eng. Technol. 2018, 7, 106–112. [Google Scholar] [CrossRef]
- Hovhannisyan, A.; Janik, M.; Woszczak, L.; Khachatryan, G.; Krystyjan, M.; Lenart-Boroń, A.; Stankiewicz, K.; Czernecka, N.; Duraczyńska, D.; Oszczęda, Z. The Preparation of Silver and Gold Nanoparticles in Hyaluronic Acid and the Influence of Low-Pressure Plasma Treatment on Their Physicochemical and Microbiological Properties. Int. J. Mol. Sci. 2023, 24, 17285. [Google Scholar] [CrossRef]
- Krystyjan, M.; Khachatryan, G.; Grabacka, M.; Krzan, M.; Witczak, M.; Grzyb, J.; Woszczak, L. Physicochemical, bacteriostatic, and biological properties of starch/chitosan polymer composites modified by graphene oxide, designed as new bionanomaterials. Polymers 2021, 13, 2327. [Google Scholar] [CrossRef] [PubMed]
- Taqi, A.; Askar, K.A.; Nagy, K.; Mutihac, L.; Stamatin, L. Effect of different concentrations of olive oil and oleic acid on the mechanical properties of albumen (egg white) edible films. Afr. J. Biotechnol. 2011, 10, 12963–12972. [Google Scholar] [CrossRef]
- Sánchez-González, L.; Chiralt, A.; González-Martínez, C.; Cháfer, M. Effect of essential oils on properties of film forming emulsions and films based on hydroxypropylmethylcellulose and chitosan. J. Food Eng. 2011, 105, 246–253. [Google Scholar] [CrossRef]
- Gallo, J.-A.Q.; Debeaufort, F.; Callegarin, F.; Voilley, A. Lipid hydrophobicity, physical state and distribution effects on the properties of emulsion-based edible films. J. Membr. Sci. 2000, 180, 37–46. [Google Scholar] [CrossRef]
- Tarique, J.; Sapuan, S.; Khalina, A. Effect of glycerol plasticizer loading on the physical, mechanical, thermal, and barrier properties of arrowroot (Maranta arundinacea) starch biopolymers. Sci. Rep. 2021, 11, 13900. [Google Scholar] [CrossRef]
- Mali, S.; Grossmann, M.V.E.; García, M.A.; Martino, M.N.; Zaritzky, N.E. Effects of controlled storage on thermal, mechanical and barrier properties of plasticized films from different starch sources. J. Food Eng. 2006, 75, 453–460. [Google Scholar] [CrossRef]
- deAraújo, G.K.P.; deSouza, S.J.; daSilva, M.V.; Yamashita, F.; Gonçalves, O.H.; Leimann, F.V.; Shirai, M.A. Physical, antimicrobial and antioxidant properties of starch-based film containing ethanolic propolis extract. Int. J. Food Sci. Technol. 2015, 50, 2080–2087. [Google Scholar] [CrossRef]
- Osuna, M.B.; Romero, C.A.; Rivas, F.P.; Judis, M.A.; Bertola, N.C. Apple pectin based film with Apis mellifera Honey and/or propolis extract as sources of active compounds. Food Biophys. 2025, 20, 13. [Google Scholar] [CrossRef]
- Marangoni Júnior, L.; Gonçalves, S.d.Á.; Silva, R.G.d.; Martins, J.T.; Vicente, A.A.; Alves, R.M.V.; Vieira, R.P. Effect of green propolis extract on functional properties of active pectin-based films. Food Hydrocoll. 2022, 131, 107746. [Google Scholar] [CrossRef]
- Salimi, A.; Khodaiyan, F.; Askari, G.; Amraei, A. Effect of propolis extract-loaded films made of apple pomace pectin and grass pea protein on the shelf life extension of black mulberry. Food Hydrocoll. 2025, 158, 110549. [Google Scholar] [CrossRef]
- Stanisławska, N.; Khachatryan, G.; Khachatryan, K.; Krystyjan, M.; Makarewicz, M.; Krzan, M. Formation and investigation of physicochemical and microbiological properties of biocomposite films containing turmeric extract nano/microcapsules. Polymers 2023, 15, 919. [Google Scholar] [CrossRef]
- Gueli, A.M.; Bonfiglio, G.; Pasquale, S.; Troja, S.O. Effect of particle size on pigments colour. Color Res. Appl. 2017, 42, 236–243. [Google Scholar] [CrossRef]
- Muñoz-Gimena, P.F.; Aragón-Gutiérrez, A.; Blázquez-Blázquez, E.; Arrieta, M.P.; Rodríguez, G.; Peponi, L.; López, D. Avocado Seed Starch-Based Films Reinforced with Starch Nanocrystals. Polymers 2024, 16, 2868. [Google Scholar] [CrossRef]
- Ruiz-López, J.; Espinar, C.; Lucena, C.; de la Cruz Cardona, J.; Pulgar, R.; Pérez, M.M. Effect of thickness on color and translucency of a multi-color polymer-infiltrated ceramic-network material. J. Esthet. Restor. Dent. 2023, 35, 381–389. [Google Scholar] [CrossRef]
- Folentarska, A.; Łagiewka, J.; Krystyjan, M.; Ciesielski, W. Biodegradable binary and ternary complexes from renewable raw materials. Polymers 2021, 13, 2925. [Google Scholar] [CrossRef] [PubMed]
- Okińczyc, P.; Widelski, J.; Szperlik, J.; Żuk, M.; Mroczek, T.; Skalicka-Woźniak, K.; Sakipova, Z.; Widelska, G.; Kuś, P.M. Impact of plant origin on eurasian propolis on phenolic profile and classical antioxidant activity. Biomolecules 2021, 11, 68. [Google Scholar] [CrossRef]
- Bal, L.M.; Meda, V.; Naik, S.; Satya, S. Sea buckthorn berries: A potential source of valuable nutrients for nutraceuticals and cosmoceuticals. Food Res. Int. 2011, 44, 1718–1727. [Google Scholar] [CrossRef]
- Iijima, M.; Nakamura, K.; Hatakeyama, T.; Hatakeyama, H. Phase transition of pectin with sorbed water. Carbohydr. Polym. 2000, 41, 101–106. [Google Scholar] [CrossRef]
- Matsuda, A.H.; Machado, L.B.; del Mastro, N.L. Thermal analysis applied to irradiated propolis. Radiat. Phys. Chem. 2002, 63, 353–355. [Google Scholar] [CrossRef]
- Da Silva, F.C.; Favaro-Trindade, C.S.; de Alencar, S.M.; Thomazini, M.; Balieiro, J.C. Physicochemical properties, antioxidant activity and stability of spray-dried propolis. J. ApiProduct ApiMedical Sci. 2011, 3, 94–100. [Google Scholar] [CrossRef]
- Huang, J.; Hu, Z.; Hu, L.; Li, G.; Yao, Q.; Hu, Y. Pectin-based active packaging: A critical review on preparation, physical properties and novel application in food preservation. Trends Food Sci. Technol. 2021, 118, 167–178. [Google Scholar] [CrossRef]
- Nisar, T.; Wang, Z.-C.; Yang, X.; Tian, Y.; Iqbal, M.; Guo, Y. Characterization of citrus pectin films integrated with clove bud essential oil: Physical, thermal, barrier, antioxidant and antibacterial properties. Int. J. Biol. Macromol. 2018, 106, 670–680. [Google Scholar] [CrossRef] [PubMed]
- Einhorn-Stoll, U.; Kunzek, H. Thermoanalytical characterisation of processing-dependent structural changes and state transitions of citrus pectin. Food Hydrocoll. 2009, 23, 40–52. [Google Scholar] [CrossRef]
- Filho, L.B.; Lima, S.K.R.; de, S. Barbosa, H. Ultrasound-assisted extraction of pectin from Spondias purpurea L. peels residues: Optimization, characterization, and comparison with commercial pectin. J. Food Meas. Charact. 2024, 18, 4634–4652. [Google Scholar] [CrossRef]
- Hunter, R.J. Zeta Potential in Colloid Science: Principles and Applications; Academic Press: Cambridge, MA, USA, 2013; Volume 2. [Google Scholar]
- Delgado, Á.V.; González-Caballero, F.; Hunter, R.; Koopal, L.; Lyklema, J. Measurement and interpretation of electrokinetic phenomena. J. Colloid Interface Sci. 2007, 309, 194–224. [Google Scholar] [CrossRef]
- Gouin, S. Microencapsulation: Industrial appraisal of existing technologies and trends. Trends Food Sci. Technol. 2004, 15, 330–347. [Google Scholar] [CrossRef]
- Zielińska, A.; Nowak, I. Abundance of active ingredients in sea-buckthorn oil. Lipids Health Dis. 2017, 16, 95. [Google Scholar] [CrossRef] [PubMed]
- Falcão, S.I.; Vale, N.; Gomes, P.; Domingues, M.R.; Freire, C.; Cardoso, S.M.; Vilas-Boas, M. Phenolic profiling of Portuguese propolis by LC–MS spectrometry: Uncommon propolis rich in flavonoid glycosides. Phytochem. Anal. 2013, 24, 309–318. [Google Scholar] [CrossRef]
- Falcão, S.I.; Vilas-Boas, M.; Estevinho, L.M.; Barros, C.; Domingues, M.R.; Cardoso, S.M. Phenolic characterization of Northeast Portuguese propolis: Usual and unusual compounds. Anal. Bioanal. Chem. 2010, 396, 887–897. [Google Scholar] [CrossRef]
- Pellati, F.; Orlandini, G.; Pinetti, D.; Benvenuti, S. HPLC-DAD and HPLC-ESI-MS/MS methods for metabolite profiling of propolis extracts. J. Pharm. Biomed. Anal. 2011, 55, 934–948. [Google Scholar] [CrossRef]
- Saftić, L.; Peršurić, Ž.; Fornal, E.; Pavlešić, T.; Pavelić, S.K. Targeted and untargeted LC-MS polyphenolic profiling and chemometric analysis of propolis from different regions of Croatia. J. Pharm. Biomed. Anal. 2019, 165, 162–172. [Google Scholar] [CrossRef] [PubMed]
- Karagecili, H.; Yılmaz, M.A.; Ertürk, A.; Kiziltas, H.; Güven, L.; Alwasel, S.H.; Gulcin, İ. Comprehensive metabolite profiling of Berdav propolis using LC-MS/MS: Determination of antioxidant, anticholinergic, antiglaucoma, and antidiabetic effects. Molecules 2023, 28, 1739. [Google Scholar] [CrossRef]
- Nichitoi, M.M.; Josceanu, A.M.; Isopescu, R.D.; Isopencu, G.O.; Geana, E.-I.; Ciucure, C.T.; Lavric, V. Polyphenolics profile effects upon the antioxidant and antimicrobial activity of propolis extracts. Sci. Rep. 2021, 11, 20113. [Google Scholar] [CrossRef]
- Medana, C.; Carbone, F.; Aigotti, R.; Appendino, G.; Baiocchi, C. Selective analysis of phenolic compounds in propolis by HPLC-MS/MS. Phytochem. Anal. Int. J. Plant Chem. Biochem. Tech. 2008, 19, 32–39. [Google Scholar] [CrossRef]
- Osés, S.M.; Marcos, P.; Azofra, P.; de Pablo, A.; Fernández-Muíño, M.Á.; Sancho, M.T. Phenolic profile, antioxidant capacities and enzymatic inhibitory activities of propolis from different geographical areas: Needs for analytical harmonization. Antioxidants 2020, 9, 75. [Google Scholar] [CrossRef]
- Duca, A.; Sturza, A.; Moacă, E.-A.; Negrea, M.; Lalescu, V.-D.; Lungeanu, D.; Dehelean, C.-A.; Muntean, D.-M.; Alexa, E. Identification of resveratrol as bioactive compound of propolis from western Romania and characterization of phenolic profile and antioxidant activity of ethanolic extracts. Molecules 2019, 24, 3368. [Google Scholar] [CrossRef]
- Danielski, R.; Shahidi, F. Phenolic composition and bioactivities of sea buckthorn (Hippophae rhamnoides L.) fruit and seeds: An unconventional source of natural antioxidants in North America. J. Sci. Food Agric. 2024, 104, 5553–5564. [Google Scholar] [CrossRef]
- Salama, S.A.; Essam, D.; Tagyan, A.I.; Farghali, A.A.; Khalil, E.M.; Abdelaleim, Y.F.; Hozzein, W.N.; Mubarak, M.; Nasr, F.A.; Eweis, A.A. Novel composite of nano zinc oxide and nano propolis as antibiotic for antibiotic-resistant bacteria: A promising approach. Sci. Rep. 2024, 14, 20894. [Google Scholar] [CrossRef]
- Sforcin, J.M.; Bankova, V.; Kuropatnicki, A.K. Medical benefits of honeybee products. Evid.-Based Complement. Altern. Med. eCAM 2017, 2017, 2702106. [Google Scholar] [CrossRef]
- Przybyłek, I.; Karpiński, T.M. Antibacterial properties of propolis. Molecules 2019, 24, 2047. [Google Scholar] [CrossRef] [PubMed]
- Bhatti, N.; Hajam, Y.A.; Mushtaq, S.; Kaur, L.; Kumar, R.; Rai, S. A review on dynamic pharmacological potency and multifaceted biological activities of propolis. Discov. Sustain. 2024, 5, 185. [Google Scholar] [CrossRef]
- Negi, P.; Chauhan, A.; Sadia, G.; Rohinishree, Y.; Ramteke, R. Antioxidant and antibacterial activities of various seabuckthorn (Hippophae rhamnoides L.) seed extracts. Food Chem. 2005, 92, 119–124. [Google Scholar] [CrossRef]
- Sandulachi, E.; Macari, A.; Cojocari, D.; Balan, G.; Popa, S.; Turculeț, N.; Ghendov-Moşanu, A.; Sturza, R. Antimicrobial properties of sea buckthorn grown in the Republic of Moldova. J. Eng. Sci. 2022, 29, 164–175. [Google Scholar] [CrossRef] [PubMed]
- Yue, X.-F.; Shang, X.; Zhang, Z.-J.; Zhang, Y.-N. Phytochemical composition and antibacterial activity of the essential oils from different parts of sea buckthorn (Hippophae rhamnoides L.). J. Food Drug Anal. 2017, 25, 327–332. [Google Scholar] [CrossRef]
- Rajkowska, K.; Rykała, E.; Czyżowska, A. Antibacterial Effect of Sea Buckthorn (Hippophae rhamnoides L.) Fruit Extract on Radish Seeds Prior to Sprouting. Pol. J. Food Nutr. Sci. 2024, 74, 120–129. [Google Scholar] [CrossRef]
- Ashurst, J.V.; Weiss, E.; Tristram, D.; Edgerley-Gibb, L. Streptococcal Pharyngitis. In StatPearls [Internet]; Updated 15 February 2025; StatPearls Publishing: Treasure Island, FL, USA, 2025. Available online: https://www.ncbi.nlm.nih.gov/books/NBK525997/ (accessed on 21 April 2025).
- Tanuğur Samanci, A.E.; Bayar Muluk, N.; Samanci, T.; Cingi, C. Pulmonary Effects of Propolis. In Propolis: Prevention and Healing Effects in Otorhinolaryngology; Springer: Berlin/Heidelberg, Germany, 2024; pp. 135–147. [Google Scholar]
- Jensen, A.; Fagö-Olsen, H.; Sørensen, C.H.; Kilian, M. Molecular mapping to species level of the tonsillar crypt microbiota associated with health and recurrent tonsillitis. PLoS ONE 2013, 8, e56418. [Google Scholar] [CrossRef]
- Cavalcanti, V.P.; Camargo, L.A.d.; Moura, F.S.; Melo Fernandes, E.J.d.; Lamaro-Cardoso, J.; Braga, C.A.d.S.B.; André, M.C.P. Staphylococcus aureus in tonsils of patients with recurrent tonsillitis: Prevalence, susceptibility profile, and genotypic characterization. Braz. J. Infect. Dis. 2019, 23, 8–14. [Google Scholar] [CrossRef]
- Su, Y.-W.; Huang, W.-H.; Yeh, C.-F. Pantoea dispersa rhinosinusitis: Clinical aspects of a rare sinonasal pathogen. Eur. Arch. Oto-Rhino-Laryngol. 2022, 279, 4389–4395. [Google Scholar] [CrossRef] [PubMed]
- Almuhayawi, M.S. Propolis as a novel antibacterial agent. Saudi J. Biol. Sci. 2020, 27, 3079–3086. [Google Scholar] [CrossRef] [PubMed]
- Krystyjan, M.; Khachatryan, G.; Ciesielski, W.; Buksa, K.; Sikora, M. Preparation and characteristics of mechanical and functional properties of starch/Plantago psyllium seeds mucilage films. Starch-Stärke 2017, 69, 1700014. [Google Scholar] [CrossRef]
- ISO 527-1:2019. Determination of Tensile Properties–Part 1: General Principles. Available online: https://www.iso.org/standard/75824.html (accessed on 25 May 2021).
- Pathare, P.B.; Opara, U.L.; Al-Said, F.A.-J. Colour measurement and analysis in fresh and processed foods: A review. Food Bioprocess Technol. 2013, 6, 36–60. [Google Scholar] [CrossRef]
- Sant’Anna, V.; Gurak, P.D.; Marczak, L.D.F.; Tessaro, I.C. Tracking bioactive compounds with colour changes in foods—A review. Dye. Pigment. 2013, 98, 601–608. [Google Scholar] [CrossRef]
- Khachatryan, G.; Khachatryan, K.; Krystyjan, M.; Krzan, M.; Khachatryan, L. Functional properties of composites containing silver nanoparticles embedded in hyaluronan and hyaluronan-lecithin matrix. Int. J. Biol. Macromol. 2020, 149, 417–423. [Google Scholar] [CrossRef]
- Owens, D.K.; Wendt, R. Estimation of the surface free energy of polymers. J. Appl. Polym. Sci. 1969, 13, 1741–1747. [Google Scholar] [CrossRef]
- Rudawska, A.; Jacniacka, E. Analysis for determining surface free energy uncertainty by the Owen–Wendt method. Int. J. Adhes. Adhes. 2009, 29, 451–457. [Google Scholar] [CrossRef]
- Re, R.; Pellegrini, N.; Proteggente, A.; Pannala, A.; Yang, M.; Rice-Evans, C. Antioxidant activity applying an improved ABTS radical cation decolorization assay. Free Radic. Biol. Med. 1999, 26, 1231–1237. [Google Scholar] [CrossRef] [PubMed]
- Yen, G.-C.; Chen, H.-Y. Antioxidant activity of various tea extracts in relation to their antimutagenicity. J. Agric. Food Chem. 1995, 43, 27–32. [Google Scholar] [CrossRef]
- Benzie, I.F.; Strain, J.J. The ferric reducing ability of plasma (FRAP) as a measure of “antioxidant power”: The FRAP assay. Anal. Biochem. 1996, 239, 70–76. [Google Scholar] [CrossRef] [PubMed]
- Vl, S. Analysis of total phenols and other oxidation substrates and antioxidants by means of Folin-Ciocalteu reagent. Methods Enzymol. 1999, 299, 152–178. [Google Scholar]

| Sample | Thickness (mm) | TS (MPa) | EAB (%) |
|---|---|---|---|
| Control | 0.362 ± 0.089 c | 4.32 ± 0.31 a | 15.90 ± 3.77 a |
| P1 | 0.650 ± 0.052 b | 1.50 ± 0.22 b | 5.92 ± 0.32 b |
| P2 | 1.404 ± 0.075 a | 0.78 ± 0.16 c | 8.80 ± 0.96 b |
| Sample | L* (D65) | a* (D65) | b* (D65) | C* | h* |
|---|---|---|---|---|---|
| Control | 93.19 ± 1.33 a | 1.74 ± 0.58 b | 15.51 ± 3.21 c | 15.61 ± 3.26 c | 1.46 ± 0.01 a |
| P1 | 56.39 ± 0.28 b | 25.85 ± 0.10 a | 50.77 ± 0.47 a | 56.97 ± 0.41 a | 1.10 ± 0.00 b |
| P2 | 49.79 ± 1.01 c | 25.63 ± 0.58 a | 39.78 ± 1.83 b | 47.32 ± 1.83 b | 1.00 ± 0.01 c |
| Sample | Form | Tong | Tmidg | Tinfg | Tendg | −∆cp |
|---|---|---|---|---|---|---|
| °C | °C | °C | °C | °C | ||
| Control | Composite | 71.1 ± 2.8 ab | 81.2 ± 0.3 b | 75.2 ± 1.5 ab | 98.3 ± 9.8 b | 0.100 ± 0.009 b |
| Lyophilisate | 52.5 ± 2.1 a | 57.2 ± 1.9 a | 59.6 ± 0.2 a | 62.7 ± 0.4 a | 0.053 ± 0.009 a | |
| P1 | Composite | 89.1 ± 23.3 bc | 103.5 ± 10.1 c | 98.3 ± 19.7 bc | 110.2 ± 6.2 bc | 0.309 ± 0.012 e |
| Lyophilisate | 107.7 ± 17.2 cd | 118.1 ± 10.2 cd | 115.2 ± 12.5 cd | 121.7 ± 11.4 cd | 0.244 ± 0.021 d | |
| P2 | Composite | 95.4 ± 16.9 bcd | 103.2 ± 10.8 c | 106.1 ± 8.8 cd | 108.9 ± 7.4 bc | 0.154 ± 0.005 c |
| Lyophilisate | 123.7 ± 0.4 d | 128.5 ± 0.9 d | 130.1 ± 2.1 d | 133.4 ± 2.2 d | 0.403 ± 0.015 f | |
| One-way ANOVA—p | 0.014 | <0.001 | 0.002 | 0.001 | <0.001 | |
| Two-way ANOVA—p | ||||||
| Factor A (Form) | 0.277 | 0.267 | 0.198 | 0.977 | 0.001 | |
| Factor B (Sample) | 0.005 | <0.001 | 0.001 | <0.001 | <0.001 | |
| Factor A × Factor B | 0.112 | 0.007 | 0.068 | 0.003 | <0.001 | |
| Sample | Form | Tonm | Tpm | Tendm | −∆Hm | Tpe |
|---|---|---|---|---|---|---|
| °C | °C | °C | J·g−1 | °C | ||
| Control | Composite | 186.6 ± 1.0 bc | 191.4 ± 0.9 b | 198.0 ± 0.6 | 227.2 ± 4.7 d | 251.6 ± 0.1 |
| Lyophilisate | 136.4 ± 3.5 a | 165.4 ± 2.0 a | 190.8 ± 7.6 | 238.5 ± 20.4 d | 242.2 ± 3.3 | |
| P1 | Composite | 175.0 ± 0.1 bc | 181.4 ± 0.3 ab | 194.1 ± 0.9 | 148.6 ± 14.9 c | 250.6 ± 0.1 |
| Lyophilisate | 173.4 ± 14.2 b | 190.5 ± 12.3 b | 206.1 ± 6.1 | 104.3 ± 3.2 b | 249.5 ± 4.5 | |
| P2 | Composite | 185.7 ± 1.8 bc | 191.4 ± 1.7 b | 200.6 ± 1.8 | 100.0 ± 1.6 b | 250.5 ± 0.4 |
| Lyophilisate | 193.5 ± 9.7 c | 198.3 ± 9.3 b | 204.6 ± 8.6 | 54.1 ± 13.1 a | 249.5 ± 1.6 | |
| One-way ANOVA—p | 0.003 | 0.032 | 0.116 | <0.001 | 0.092 | |
| Two-way ANOVA—p | ||||||
| Factor A (Form) | 0.019 | 0.455 | 0.369 | 0.004 | 0.045 | |
| Factor B (Sample) | 0.007 | 0.049 | 0.165 | <0.001 | 0.250 | |
| Factor A × Factor B | 0.004 | 0.021 | 0.094 | 0.012 | 0.108 | |
| Size [nm] | Zeta Potential [mV] | |
|---|---|---|
| Control | 100 | −18.0 |
| P1 | 4440 | −14.5 |
| P2 | 6250 | −12.5 |
| Sample | Contact Angle | Surface Free Energy | |||
|---|---|---|---|---|---|
| Water | Diiodomethane | Polar (mJ/m2) | Dispersive (mJ/m2) | Total Free Energy (mJ/m2) | |
| Control | 82.1 | 40.8 | 2.40 | 42.25 | 44.65 |
| P1 | 75.5 | 26.8 | 3.55 | 47.23 | 50.78 |
| P2 | 80.3 | 32.6 | 2.36 | 45.72 | 48.08 |
| Samples | ABTS+ [mmolTE/100 g] | DPPH [mmolTE/100 g] | FRAP [mmolTE/100 g] | TPC [mgGAE/100 g] |
|---|---|---|---|---|
| Control | 0.77 a ± 0.17 | 0.08 a ± 0.00 | 0.21 a ± 0.01 | 35.47 a ± 0.37 |
| P1 | 67.93 b ± 3.85 | 12.870 b ± 1.68 | 13.93 b ± 0.40 | 3726.26 b ± 40.85 |
| P2 | 108.90 c ± 3.09 | 22.83 c ± 3.97 | 25.66 c ± 4.52 | 7077.59 c ± 139.88 |
| Compound | Rt | λmax | [M − H] m/z | Concentration µg/g Biocomposites | |||
|---|---|---|---|---|---|---|---|
| min | nm | MS | MS/MS | P1 | P2 | ||
| 1 | Caffeic acid | 2.14 | 324 | 179 | 135 | 298.62 ± 0.00 | 460.69 ± 6.95 |
| 2 | Protocatechuic acid | 2.20 | 253 | 153 | - | 419.44 ± 5.61 | 718.78 ± 9.61 |
| 3 | Coumaric acid | 2.57 | 309 | 163 | 119 | 336.33 ± 10.85 | 414.54 ± 13.37 |
| 4 | Coumaric acid | 2.60 | 309 | 163 | 119 | 590.13 ± 11.92 | 979.91 ± 19.79 |
| 5 | Ferulic acid | 2.80 | 295, 322 | 193 | 133 | 217.55 ± 1.97 | 417.88 ± 3.77 |
| 6 | Isoferulic acid | 2.88 | 298, 320 | 193 | 133 | 310.09 ± 2.22 | 512.96 ± 3.68 |
| 8 | Salicilic acid deriv. | 3.28 | 269 | 331 | 269 | 284.81 ± 10.11 | 417.61 ± 14.82 |
| 9 | Caftaric acid | 3.47 | 321 | 311 | 149 | 895.90 ± 13.03 | 1330.31 ± 19.35 |
| 10 | Elagic acid | 3.52 | 367 | 301 | 257 | 323.57 ± 10.92 | 524.26 ± 17.70 |
| 11 | Isorhamnetin/Rhamnetin | 3.72 | 255, 355 | 315 | 300 | 445.25 ± 1.69 | 662.17 ± 2.52 |
| 12 | Pinobanksin-5-methyl ether | 3.80 | 286 | 285 | 267, 252 | 1808.63 ± 48.74 | 2719.11 ± 73.28 |
| 13 | Apigenin | 3.90 | 267, 333 | 269 | 225, 151 | 779.69 ± 13.83 | 1022.16 ± 18.13 |
| 14 | Unknown | 3.94 | 281 | 345 | 207 | 618.63 ± 27.89 | 751.75 ± 33.89 |
| 15 | Kaempferol | 3.97 | 265, 366 | 285 | 257 | 843.44 ± 1.23 | 1264.78 ± 1.85 |
| 16 | Pinobanksin | 4.12 | 291 | 271 | 253, 225 | 2322.89 ± 81.52 | 3130.48 ± 109.87 |
| 17 | Kaempferol-methyl eter | 4.17 | 267, 349 | 299 | 284 | 683.55 ± 6.59 | 977.22 ± 9.42 |
| 18 | Pinocembrin-5-methyl ether | 4.21 | 285 | 269 | 255, 227 | 336.45 ± 23.11 | 330.72 ± 22.72 |
| 19 | Quercetin-dimethyl ether isomer I | 4.29 | 255, 353 | 329 | 271 | 591.43 ± 6.89 | 686.60 ± 8.00 |
| 20 | Galangin-5-methyl ether | 4.51 | 260, 350 | 283 | 268, 239 | 994.51 ± 27.51 | 1212.05 ± 33.52 |
| 21 | Isorhamnetin/Rhamnetin | 4.56 | 255, 364 | 315 | 300 | 598.82 ± 7.69 | 736.19 ± 9.46 |
| 22 | Coumaric acid deriv. | 4.66 | 309 | 535 | 163 | 2727.17 ± 47.43 | 4043.24 ± 70.32 |
| 23 | Quercetin-dimethyl ether isomer II | 4.76 | 255, 355 | 329 | 271 | 522.74 ± 13.03 | 635.66 ± 15.84 |
| 24 | Caffeic acid benzyl ester | 4.98 | 267, 315 | 269 | 178, 134 | 10,599.40 ± 207.28 | 14,340.08 ± 280.43 |
| 25 | Pinocembrin | 5.08 | 290 | 255 | 227 | 6581.06 ± 275.06 | 6446.82 ± 269.45 |
| 26 | Galangin | 5.10 | 265, 300 sh, 360 | 269 | 241, 227 | 8039.77 ± 150.25 | 13,908.89 ± 259.93 |
| 27 | Pinobanksin-3-O-acetate | 5.16 | 293 | 313 | 271, 253 | 5039.57 ± 260.62 | 7607.64 ± 393.42 |
| 28 | Caffeic acid phenylethyl ester | 5.21 | 296, 327 | 283 | 179, 135 | 1538.70 ± 61.08 | 2394.20 ± 95.04 |
| 29 | Methoxy-chrysin | 5.33 | 266, 310 sh, 340 sh | 283 | 268 | 1089.68 ± 16.98 | 1576.91 ± 24.57 |
| 30 | Caffeic acid cinnamyl ester | 5.50 | 295, 321 | 295 | 253 | 2577.78 ± 45.32 | 3539.57 ± 62.22 |
| 31 | Pinobanksin 3-O-propionate | 5.63 | 293 | 327 | 271, 253 | 2335.50 ± 88.21 | 3185.17 ± 120.30 |
| 32 | Caffeic acid deriv. | 5.72 | 322 | 501 | 353 | 918.47 ± 27.76 | 1273.08 ± 38.48 |
| 33 | Unknown | 5.81 | 291 | 319 | 269 | 423.85 ± 5.43 | 521.90 ± 6.69 |
| 34 | Pinobanksin-7-methyl ether-5-O-p-hydroksyphenylpropionate | 5.90 | 291 | 475 | 433, 415 | 364.01 ± 17.34 | 596.58 ± 28.42 |
| 35 | Acetylated coumaric acid deriv. | 5.97 | 310 | 325 | 279, 163 | 1647.42 ± 3.68 | 2272.45 ± 5.07 |
| 36 | Pinobanksin-3-O-butyrate or isobutyrate | 6.08 | 293 | 341 | 271, 253 | 1521.73 ± 30.40 | 2232.98 ± 44.61 |
| 37 | Unknown | 6.20 | 288 | 325 | 265 | 729.49 ± 41.45 | 1114.72 ± 63.34 |
| 38 | Unknown | 6.22 | 267 | 325 | 269 | 1296.64 ± 3.84 | 1761.43 ± 5.22 |
| 39 | Unknown | 6.29 | 266, 300 sh, 350 | 325 | 265 | 343.52 ± 2.41 | 488.61 ± 3.43 |
| 40 | Pinobanksin-3-O-pentanoate or 2-methylbuturate | 6.47 | 291 | 355 | 271, 253 | 272.16 ± 3.31 | 409.08 ± 4.98 |
| 41 | Pinobanksin-3-O-hexenoate | 6.54 | 291 | 367 | 271, 253 | 101.69 ± 2.20 | 166.00 ± 3.60 |
| 42 | Pinobanksin-3-O-phenylpropionate hexenoate | 6.59 | 291 | 403 | 271, 253 | 302.61 ± 3.19 | 424.45 ± 4.48 |
| 43 | Pinobanksin-3-O-hexanoate | 6.83 | 291 | 369 | 271, 253 | 143.08 ± 1.49 | 202.05 ± 2.20 |
| Total | 65,308.53 ± 251.33 | 91,892.41 ± 625.46 | |||||
Disclaimer/Publisher’s Note: The statements, opinions and data contained in all publications are solely those of the individual author(s) and contributor(s) and not of MDPI and/or the editor(s). MDPI and/or the editor(s) disclaim responsibility for any injury to people or property resulting from any ideas, methods, instructions or products referred to in the content. |
© 2025 by the authors. Licensee MDPI, Basel, Switzerland. This article is an open access article distributed under the terms and conditions of the Creative Commons Attribution (CC BY) license (https://creativecommons.org/licenses/by/4.0/).
Share and Cite
Woszczak, L.; Khachatryan, G.; Khachatryan, K.; Witczak, M.; Lenart-Boroń, A.; Stankiewicz, K.; Dworak, K.; Adamczyk, G.; Pawłowska, A.; Kapusta, I.; et al. Synthesis and Investigation of Physicochemical and Microbial Properties of Composites Containing Encapsulated Propolis and Sea Buckthorn Oil in Pectin Matrix. Int. J. Mol. Sci. 2025, 26, 8664. https://doi.org/10.3390/ijms26178664
Woszczak L, Khachatryan G, Khachatryan K, Witczak M, Lenart-Boroń A, Stankiewicz K, Dworak K, Adamczyk G, Pawłowska A, Kapusta I, et al. Synthesis and Investigation of Physicochemical and Microbial Properties of Composites Containing Encapsulated Propolis and Sea Buckthorn Oil in Pectin Matrix. International Journal of Molecular Sciences. 2025; 26(17):8664. https://doi.org/10.3390/ijms26178664
Chicago/Turabian StyleWoszczak, Liliana, Gohar Khachatryan, Karen Khachatryan, Mariusz Witczak, Anna Lenart-Boroń, Klaudia Stankiewicz, Kinga Dworak, Greta Adamczyk, Agata Pawłowska, Ireneusz Kapusta, and et al. 2025. "Synthesis and Investigation of Physicochemical and Microbial Properties of Composites Containing Encapsulated Propolis and Sea Buckthorn Oil in Pectin Matrix" International Journal of Molecular Sciences 26, no. 17: 8664. https://doi.org/10.3390/ijms26178664
APA StyleWoszczak, L., Khachatryan, G., Khachatryan, K., Witczak, M., Lenart-Boroń, A., Stankiewicz, K., Dworak, K., Adamczyk, G., Pawłowska, A., Kapusta, I., Krzan, M., Godlewska, M., & Krystyjan, M. (2025). Synthesis and Investigation of Physicochemical and Microbial Properties of Composites Containing Encapsulated Propolis and Sea Buckthorn Oil in Pectin Matrix. International Journal of Molecular Sciences, 26(17), 8664. https://doi.org/10.3390/ijms26178664

